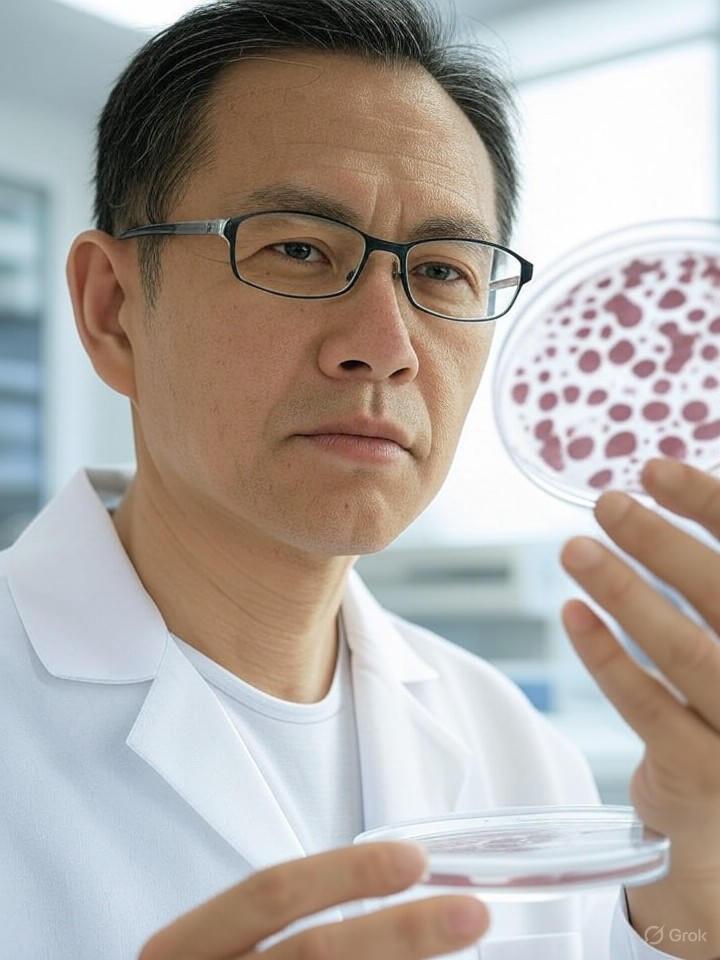
Research shows the role of alcohol in bowel damage and ALD inflammation

On Thursday, Ukrainian authorities said that Russia launched the largest drone and missile Salvo in Ukraine in more than a month, and Moscow accused Kief of not being interested in "sustainable, sustainable."
(CNN) - Russia launch the main aircraft and missile trails in Ukraine more than a month, jakrann, Yikrann's long-term. "
Nine civil groups were killed on strike, as well as in the east of Ukraine, Vladimi Putin, accompanied by European leaders and European leaders at the end of the conflict.
But since then there have been few signs of tangible progress.The Russian Foreign Minister paid cold water for guaranteeing the security of the summit and Kyiv manager, saying that the Kremlin would not accept the placement of foreign troops in Ukraine.
In night attacks, Russia put 574 droo and 40 missiles in Ukraine, President Volodymyr Zelensky said he would die in the west of Hiliviv.
Ukrainian officials claim that the missiles were also affected by Flex Limited, US manufacturers in West Juckerpathy, Ukrainian officials said Flex is an American Singapore company providing electronics production services and is located at the Austin headquarters.
"Last night Russian missiles attacked one of the largest US investments in Ukraine - flex - active members of the US Chamber of Commerce," said Andy Funder, president of the US Chamber of Commerce in Ukraine."Russia continues to destroy and embarrass the US business in Ukraine, targeting companies that invest and trade in US stock markets."
A CNN Flex spokesman said six staff remained in the hospital after the strike and stressed that the company "does not manufacture or support any military equipment".
French Alien Ministry heard Ukraine attacks and they showed "impacts seriously in Russian
In a statement, Jelenski also observed the time of Moscow's blows."The Russians made the attack as nothing changed. There is no effort from the world to prevent this war."
Zelensky said he was demanding "compromise" before talking to Russian President Vladimir Putin a day ago.
Ukraine and his allies in Europe have been pushing for a long time because there is a truce as the first step to end the war, which will require solving problems that seem to be able to reach a guarantee of land and security.
But when US President Donald Trump entered to get a "peaceful agreement" on a fast ceasefire, showing flexibility.
"The planned confidence was able to include a suspension," he said."I said to President Hon4 we will need a period of peace in any case to develop the whole end of the war - if we want the plan to be serious."
Zlansky told new newspapers on Wednesday is waiting for the Ukraine to start the "driving the" driver in front of the great
Kremlin has spilled the cold water in two meetings
However, the description of Moscow plans for bilateral conferences between Putin and Seledeki conflicts with the story of the White House.
Russian External Affairs Minister Sergey Lavarov concluded Kremlin on Thursday.
Lavrov said, "The values of a peace," the validity of the person who sign up to the agreement of the rip will be solved. "
The minister, as the Kremlin, who ended in May 2024, did not pay attention to the military conditions of the election that the elections were legally prohibited and allows them to stay in office.
He also warned against deployment of any foreign troops in Ukraine, asking him to "completely unacceptable" to Russia and "all European political strengths".
Lavrov also tried to draw a picture that was the Ukrainian side to prevent more conversations.
Ukraine "shows that he is not interested in permanent, correct and long and long," he said.
The Kremlin said Putin suggested to send higher-plant officials to negotiate the negotiation with Istanbul Ukraine
Claire Sebastian, Pierre Barren, Kristen Homes and Betsy Clain contributed to the report.